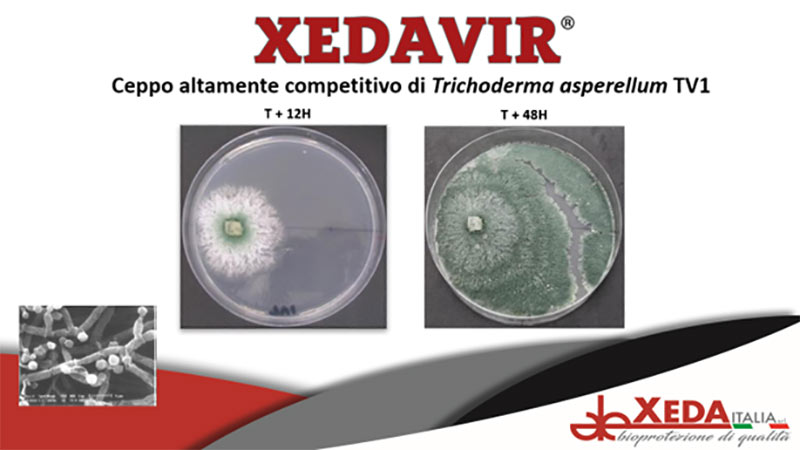

Dal campo
Periodo di trapianti, sono i marciumi radicali i nemici principali per le orticole
La soluzione si può trovare nei funghi antagonisti

I marciumi radicali sono grandi nemici delle coltivazioni orticole sotto serra: rappresentano soprattutto una minaccia per quei prodotti destinati a diventare articoli ad alto contenuto di servizio - come gli ortaggi per la IV Gamma - e, negli anni, le soluzioni agrochimiche per contrastarli sono state limitate. L'attacco fungino, se non gestito, può limitare, se non compromettere, l'intera produzione. In futuro il problema sarà sempre più grave, anche nell'ottica della continua revisione dei principi attivi ammessi. Questo nel convenzionale, mentre in agricoltura bio tutto è ancora più complicato.
Le strategie, come spiegato a IFN da Xeda Italia (clicca qui per approfondire nel sito), si possono incentrare su soluzioni naturali: altri funghi che entrano in competizione con Pythium spp., Phytophthora capsici, Rhizoctonia spp. e Verticillium spp.
“Un esempio è Trichoderma asperellum (ceppo TV1), un microrganismo che è alla base di Xedavir® (clicca qui per approfondire la brochure), il fungicida naturale di Xeda Italia", spiega Andrea Bosi, country manager di Xeda Italia. Secondo le indagini promosse dall'azienda, le performance di Xedavir® (clicca qui per approfondire la brochure) sono del tutto comparabili a quelle di un fungicida di sintesi chimica, con il vantaggio di poter essere impiegato in biologico e nella lotta integrata”.
Questo Agrofarmaco Biologico per il contenimento delle malattie fungine del terreno è molto versatile, perché presenta una notevole velocità di sviluppo in condizioni di pH, temperatura e salinità del terreno differenti; le ricerche svolte da Xeda Italia mettono poi in risalto l'alta competizione degli spazi nei confronti dei patogeni.
Il formulato di Xeda Italia fa quindi leva su un microrganismo antagonista presente in natura e non geneticamente modificato che presenta una spiccata azione di repressione e contenimento verso i responsabili dei marciumi radicali e consente un progressivo miglioramento della sanità della rizosfera.

“L’aspetto importante di Xedavir® – precisa Bosi - è utilizzabile in vivaio, in serra e anche in pieno campo, nei programmi di lotta biologica e integrata, senza nessun rischio di fitotossicità. Ciò che contraddistingue il ceppo TV1 è che, una volta applicato, mostra una spiccata rapidità di crescita e diffusione nell'ambiente circostante, anche in condizioni di pH, salinità e temperatura molto variabili. Il ceppo TV1 del Trichoderma asperellum - rim è ufficialmente depositato presso una micoteca europea ed è 100% non geneticamente modificato”.

La sostenibilità ambientale del formulato, poi, è un altro elemento interessante: Xedavir®, infatti, non richiede alcun intervallo di sicurezza né di rientro in campo ed è pertanto una soluzione ecocompatibile; da qui l'utilizzo in agricoltura biologica e in lotta integrata. Non è solo efficace contro i patogeni, ma anche selettivo nei confronti delle colture; Il contributo dei mezzi chimici è ancora fondamentale su molte colture e soprattutto nelle prime fasi di crescita delle piante, ma è altrettanto riconosciuta l’utilità di prodotti come Xedavir® nel garantire una continuità di protezione nelle fasi successive e in prossimità della raccolta, dove l’aspetto residuale diventa discriminante.

Per questo motivo e per la brevità del ciclo colturale, questo prodotto si colloca con efficacia in tutte le coltivazioni orticole a elevato contenuto di servizio, come prodotti confezionati e pronti per il consumo. Il campo di applicazione di Xedavir® comunque è ampio e spazia da tutte le colture orticole a quelle floricole, per arrivare alle piante officinali, ornamentali e tappeti erbosi. Xeda Italia consiglia l'applicazione del prodotto in una logica preventiva, quindi in presemina o pre-trapianto, oppure alla semina e al trapianto.

Xedavir® è formulato in polvere bagnabile e supportato con sostanze inerti e nutrienti che hanno il compito di mantenere stabile nella formulazione il microrganismo, presente allo stadio di crescita di micelio e clamidospore che garantiscono maggior rapidità di crescita e capacità colonizzante.

Xedavir® è miscelabile con molti prodotti insetticidi, fertilizzanti, erbicidi, e Xeda Italia è in grado di fornire una serie di tabelle di compatibilità di Trichoderma asperellum.



















